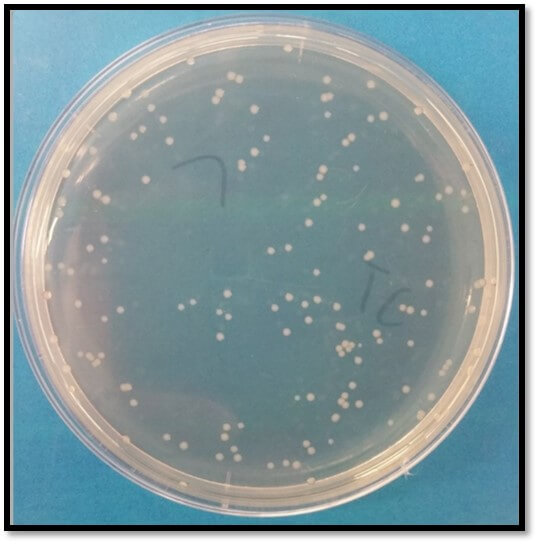

En Iyi Dis Beyazlatici Macunlar Ve Dis Sagligi Hakkinda Bilgiler Kizlarsoruyor

Antibiyotikli Bactobran Pomad Krem Nedir Ne Icin Kullanilir Krem Saglik Bakim Saglikli Yasam Tarzi

Elugel Dis Jeli 40ml

Dis Macunu Dis Macunu Sikacagi Fiyatlari Ve Cesitleri

Lr Aloe Vera Microsilver Plus Dis Macunu 75ml Amazon Com Tr

Dis Agrilarinda Hemen Antibiyotik Kullanmayin

Dis Macunu Dis Macunu Sikacagi Fiyatlari Ve Cesitleri

Dis Macunlarindaki Florur Ile Ilgili Son Durum Nedir Saglik Haberleri

Dis Macunu Dis Macunu Sikacagi Fiyatlari Ve Cesitleri

Beyazlatici Dis Macunu Yerine Bunu Kullanin Saglik Son Dakika Haberler

Dis Macunu Dis Macunu Sikacagi Fiyatlari Ve Cesitleri

Uz Dr Alatas Gunes Yanigina Dis Macunu Veya Yogurt Surmeyin

Dis Macunu Dis Macunu Sikacagi Fiyatlari Ve Cesitleri

Dis Iltihabina Ne Iyi Gelir Nasil Gecer Dis Iltihabini Giderecek Ve Kurutacak Yontemler

Dis Agrilarinda Hemen Antibiyotik Kullanmayin

Antibiyotikler Ve Dis Enfeksiyonlari Hakkinda Bilinmesi Gerekenler Onur Ozturk

Dis Macunu Dis Macunu Sikacagi Fiyatlari Ve Cesitleri

Kayseri Haberleri Uz Dr Alatas Gunes Yanigina Dis Macunu Veya Yogurt Surmeyin Yerel Haberler

Gunes Yanigina Dis Macunu Veya Yogurt Surmeyin

Dislerimizi Zehir Ile Mi Temizliyoruz Onur Ozturk

Agiz Ve Dis Sagligi

Dis Macunu Ve El Sabunu Da Superbugs Yaratiyor Universite Agi

Dis Macunu Dis Macunu Sikacagi Fiyatlari Ve Cesitleri

Dis Macunundaki Tehlike Bizim Aile Dergisi

Https Encrypted Tbn0 Gstatic Com Images Q Tbn And9gcqthz2y5wt829yws8zyhq3ghavjseo9wsn7ryujqgc Usqp Cau

Dis Eti Tedavisinde Ilk Adim Agiz Temizligi Ve Bakimi

Agiz Ve Dis Sagligi

Fito Krem Nedir Fito Krem Ne Ise Yarar

Dis Macunu Dis Macunu Sikacagi Fiyatlari Ve Cesitleri

Microsilversampuan Instagram Posts Photos And Videos Picuki Com

Https Www Klimik Org Tr Wp Content Uploads 2017 10 A C4 9f C4 B1z Mikrobiyotas C4 B1 Ve C4 B0nfektif Endokardit Nursen Top C3 87uo C4 9elu Pdf

Agiz Yarasi Nedir Agiz Yarasi Belirtileri Nelerdir

Antibiyotikler Ve Dis Enfeksiyonlari Hakkinda Bilinmesi Gerekenler Onur Ozturk

Uz Dr Alatas Gunes Yanigina Dis Macunu Veya Yogurt Surmeyin Kayseri Haberleri

Ersag Bedriye Kizilay Posts Facebook

Dis Macunu Sivilceleri Ortadan Kaldiriyor Mu Cilt Bakimi Sac Bakimi

Agiz Ve Dis Sagligi

Dis Eti Iltihabi Nasil Gecer Estetik

Https Dergipark Org Tr Tr Download Article File 278914

Dis Macunu Dis Macunu Sikacagi Fiyatlari Ve Cesitleri

Antibiyotikler Ve Dis Enfeksiyonlari Hakkinda Bilinmesi Gerekenler Onur Ozturk

Hic Bir Ilac Fayda Etmiyor Apseli Dis Agrisi Nasil Gecer Yasam

Agiz Gargarasi Markalari Ve Fiyatlari Trendyol

Agiz Yarasi Nasil Gecer Son Dakika Haberler

Sensodyne Yuzunden Dudagim Sisti Sikayetvar

Hic Bir Ilac Fayda Etmiyor Apseli Dis Agrisi Nasil Gecer Yasam

Agiz Ve Dis Sagligi

Sensodyne Yuzunden Dudagim Sisti Sikayetvar

Https Dergipark Org Tr Tr Download Article File 278914

Dis Macunundaki Sodyum Florid Tehlikesi Triklosan Zehiri

Agiz Gargarasi Markalari Ve Fiyatlari Trendyol

Sensodyne Dis Macunu Fiyati Fiyatlari

Lr Aloe Via Moments Set Lr Aloe Via Beautyandhealtylife Facebook

Yaniga Ne Iyi Gelir

Dis Macunu Dis Macunu Sikacagi Fiyatlari Ve Cesitleri

Alt Ve Yara Sikayetleri 3 12 Sikayetvar

Agiz Ve Dis Sagligi

Dis Agrilarinda Hemen Antibiyotik Kullanmayin

Evde Temizlik Urunlerini Kullanirken Nelere Dikkat Etmeliyiz

Https Dergipark Org Tr Tr Download Article File 278914

Sensodyne Dis Macunu Fiyati Fiyatlari

Bartin Uzman Dis Klinigi Dis Sagligi Ve Sistemik Hastaliklar

Dis Eti Iltihabi Icin Ev Yapimi 5 Dogal Care Sagliga Bir Adim

Actolind Yara Bakimi W Gel 50 Ml Trendyol

Dis Macunu Dis Macunu Sikacagi Fiyatlari Ve Cesitleri
Dis Macunu Ve El Sabunu Da Superbugs Yaratiyor Universite Agi

Https Dergipark Org Tr Tr Download Article File 278914

Cilt Beyazlatici Ve Leke Giderici Etkisiyle Niacinamide Vitamin B3 Hakkinda Her Sey Justin Beauty Blog

En Iyi Dis Beyazlatici Macunlar Ve Dis Sagligi Hakkinda Bilgiler Kizlarsoruyor

Balaban Krem Ne Ise Yarar Balaban Pomad Nasil Kullanilir Balaban Krem Fiyati Guzellik Haberleri Haber7

Agiz Ve Dis Sagligi

Bacitracin Merhem Ilk Yardim Antiseptik Antibiyotik Krem Tarafindan Sion Medical Yara Enfeksiyonu Onlemek Aftercare Antibakteriyel Cilt Acil Agri Kesici 144 Bireysel Paketler 0 031 Oz 0 9 G Gitmek Icin Buy Products Online

Https Www Klimik Org Tr Wp Content Uploads 2017 10 A C4 9f C4 B1z Mikrobiyotas C4 B1 Ve C4 B0nfektif Endokardit Nursen Top C3 87uo C4 9elu Pdf

Gunes Yanigina Ne Iyi Gelir Sayfa 5 Saglik Haberleri

Dogal Anneyim Ekim 2011

Dis Agrilarinda Hemen Antibiyotik Kullanmayin

Dis Macunu Dis Macunu Sikacagi Fiyatlari Ve Cesitleri

En Iyi Dis Beyazlatici Macunlar Ve Dis Sagligi Hakkinda Bilgiler Kizlarsoruyor

Koronavirus Surecinde Ev Kazalarina Dikkat Web Haber

Https Dergipark Org Tr Tr Download Article File 278914

Utalk Pudra 100 Gr Kozmela Com

Dogal Anneyim Ekim 2011

Beyazlatici Dis Macunu Yerine Bunu Kullanin Saglik Son Dakika Haberler

Agizda Tekrarlayan Aftlar Dr Jan Klod Kayuka

Dis Agrisina Ne Iyi Gelir Dis Agrisi Icin Evde Yapilacak Cozumler Saglik Haberleri

Blefarit Goz Kapagi Iltihabi Prof Dr Gokhan Gulkilik

Disleriniz Icin Dogru Bildiginiz 10 Yalnis Cerrahi Tip Merkezi Elitium A Tipi Cerrahi Merkezi Esenyurt Istanbul

Gereksiz Antibiyotik Disler De Kalici Hasar Birakiyor

Dis Macunu Dis Macunu Sikacagi Fiyatlari Ve Cesitleri

Pdf Bulasici Olmayan Kronik Hastaliklar Ve Dis Curugu

Blefarit Goz Kapagi Iltihabi Prof Dr Gokhan Gulkilik

Https Dergipark Org Tr Tr Download Article File 278914

Kurdan Kullaniminin Ne Gibi Zararlari Vardir

Gunes Yanigina Ne Iyi Gelir Sayfa 5 Saglik Haberleri

Dis Agrisi Icin Agri Kesici Ve Dis Icin Antibiyotik Isimleri 1000 Mg

Cilt Soyma Kremleri Peeling Creme Hautpflege Hautpflege Akne

Yaniklar Somuncu Baba Dergisi

Uz Dr Alatas Gunes Yanigina Dis Macunu Veya Yogurt Surmeyin Haberi Haberleri